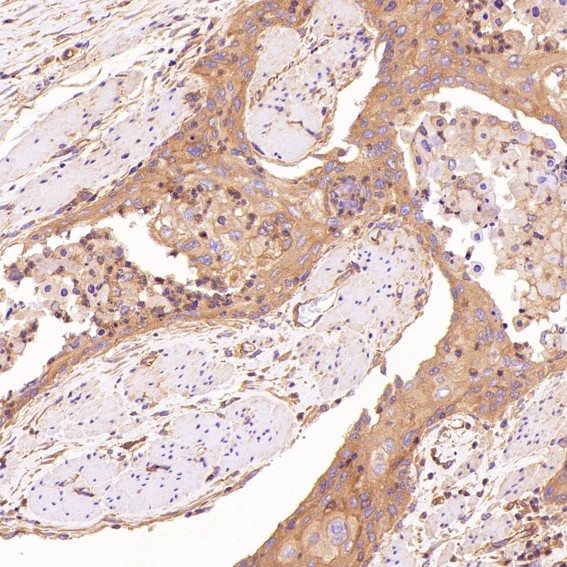
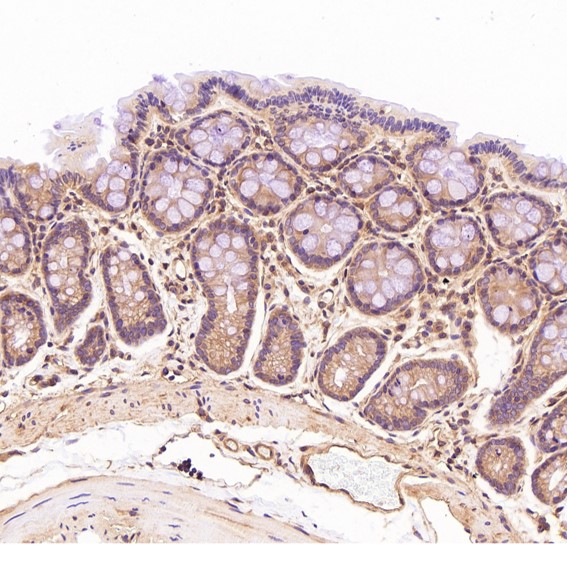
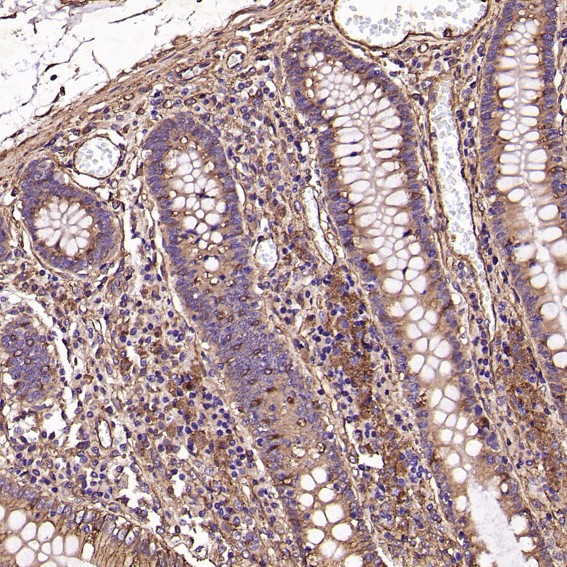

单克隆抗体
ROCK1 Antibody (CY5328)
UniProt:Q13464
Application:WB,IHC,ICC/IF,IP,FC
Reactivity:Human,Mouse,Rat
Source:Rabbit mAb
ROCK1 Antibody (CY5328)
UniProt:Q13464
Application:WB,IHC,ICC/IF,IP,FC
Reactivity:Human,Mouse,Rat
Source:Rabbit mAb
http://www.abways.cn/showproduct.asp?cid=CY5328
Androgen Receptor Antibody (CY5329)
UniProt:P10275
Application:WB,IHC,ICC/IF
Reactivity:Human,Mouse,Rat
Source:Rabbit mAb
Androgen Receptor Antibody (CY5329)
UniProt:P10275
Application:WB,IHC,ICC/IF
Reactivity:Human,Mouse,Rat
Source:Rabbit mAb
http://www.abways.cn/showproduct.asp?cid=CY5329
MMP1 Antibody (CY5330)
UniProt:P03956
Application:WB,IHC,ICC/IF,FC
Reactivity:Human
Source:Rabbit mAb
MMP1 Antibody (CY5330)
UniProt:P03956
Application:WB,IHC,ICC/IF,FC
Reactivity:Human
Source:Rabbit mAb
http://www.abways.cn/showproduct.asp?cid=CY5330
TrkA Antibody (CY5331)
UniProt:P04629
Application:WB,IHC,ICC/IF,IP,FC
Reactivity:Human,Mouse,Rat
Source:Rabbit mAb
TrkA Antibody (CY5331)
UniProt:P04629
Application:WB,IHC,ICC/IF,IP,FC
Reactivity:Human,Mouse,Rat
Source:Rabbit mAb
http://www.abways.cn/showproduct.asp?cid=CY5331
Cytokeratin 20 Antibody (CY5332)
UniProt:P35900
Application:WB,IHC,ICC/IF,IP,FC
Reactivity:Human,Rat
Source:Rabbit mAb
Cytokeratin 20 Antibody (CY5332)
UniProt:P35900
Application:WB,IHC,ICC/IF,IP,FC
Reactivity:Human,Rat
Source:Rabbit mAb
http://www.abways.cn/showproduct.asp?cid=CY5332

销售咨询
一键电话